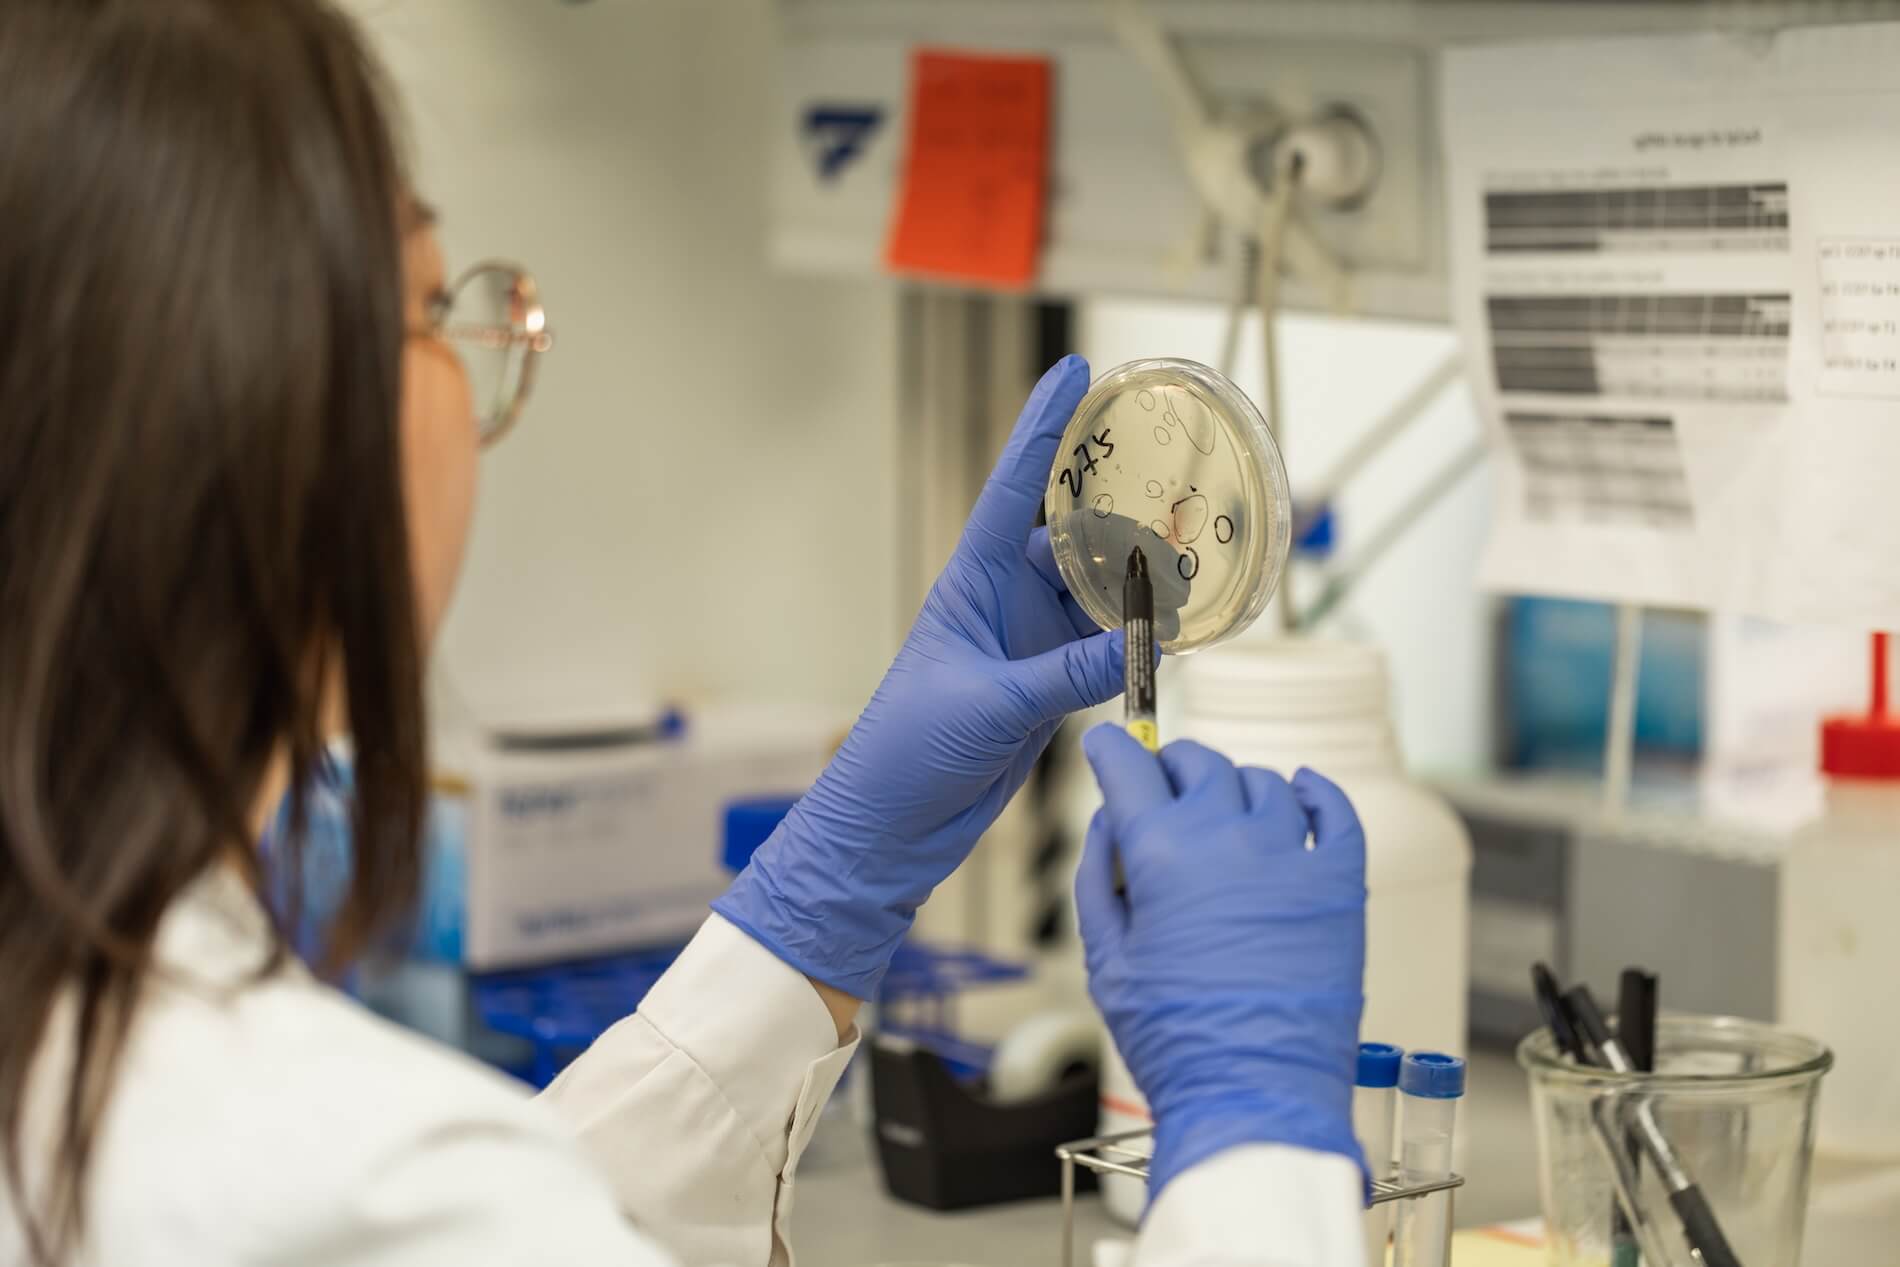

Convocatoria pionera que une investigación agraria y biomédica
Agrohealth
Agrotecnio y el Instituto de Investigación Biomédica de Lleida (IRBLleida) han unido esfuerzos para impulsar Agrohealth, una convocatoria conjunta que fomenta proyectos de investigación innovadores en la intersección entre el ámbito agrario y la investigación biomédica. Esta iniciativa pionera tiene por objetivo generar sinergias entre disciplinas para afrontar los grandes retos de la salud global con una visión interdisciplinaria y transformadora.
Hasta ahora se han celebrado dos ediciones de Agrohealth (2022 y 2024) y está previsto que la colaboración continúe y se amplíe en futuras convocatorias.
Objetivos
- Fomentar la interdisciplinariedad entre ciencias agrarias y biomédicas
- Impulsar la investigación traslacional desde el sector agroalimentario
- Mejorar la salud humana a través del conocimiento científico compartido
- Promover colaboraciones estables entre grupos de investigación
Proyectos
Agrohealth 2024: proyectos financiados

Investigadores
- Laura Rubió (Agrotecnio- Universitat de Lleida)
- Diego Arango del Corro (IRBLleida)
Resumen
El proyecto CHEMBAR estudia cómo los alimentos elaborados con cebada rica en compuestos bioactivos pueden ayudar a prevenir el cáncer colorrectal, una de las principales causas de mortalidad por cáncer a nivel mundial.
La investigación se centra en investigar y analizar los efectos de determinados componentes naturales de la cebada (como los β-glucanos, polifenoles y fibras) que tienen propiedades antitumorales, antioxidantes y antiinflamatorias. Estos compuestos pueden contribuir a reducir el riesgo de desarrollar tumores en el colon.
Investigadores
- Paul Cristou (ICREA i Agrotecnio)
- Manel Portero (IRBLleida – UdL)
Resumen
Este proyecto investiga cómo determinados compuestos naturales presentes en el arroz pueden actuar como agente microbicidas, es decir, con capacidad para combatir bacterias, virus y hongos responsables de enfermedades infecciosas.
Los investigadores analizan proteínas, péptidos y otras moléculas bioactives extraídas de diversas variedades de arroz con el objetivo de identificar su potencial antimicrobiano. Estas sustancias pueden ser útiles en la prevención o tratamiento de infecciones, especialmente en un contexto de resistencia creciente a los antibióticos y de nuevas amenazas sanitarias globales.

Investigadores
Laura Salvia (Agrotecnio – Universitat de Lleida) y Nuria Eritja (IRB Lleida – UdL)
Resumen
Este proyecto desarrolla sistemas comestibles nanoestructurados (como nanopartículas o emulsiones) para administrar betacaroteno, un compuesto antioxidante natural, con el objetivo de potencial su efecto preventivo contra el cáncer a través de la dieta.
El reto principal es mejorar la estabilidad, la biodisponibilidad y la eficacia del betacaroteno cuando se ingiere, ya que de forma natural tiene una baja solubilidad y se absorbe mal. El proyecto propone encapsularlo en sistemas nanoestructurados comestibles, que pueden incorporarse en alimentos funcionales o suplementos dietéticos.
Agrohealth 2022: Proyectos financiados

Investigadores
- Immaculada Viñas (Agrotecnio- UdL)
- José Serrano (IRB Lleida – UdL)
Resumen
El proyecto tiene por objetivo desarrollar y evaluar una estrategia de biotransformación para reducir la presencia de patulina (una micotoxina potencialmente tóxica producida por hongos) en los zumos de manzana. El estudio combina el análisis de la viabilidad tecnológica del proceso y su seguridad toxicológica con el objetivo final de mejorar la calidad y la seguridad de estos productos alimentarios.

Investigadores
- Gabriel de la Fuente (Agrotecnio-UdL)
- Ángeles de la Torre (IRBLleida – UdL)
Resumen
El proyecto utiliza cerdos de destete como modelo animal para evaluar la eficacia de una levadura modificada biotecnológicamente en la prevención de la anemia ferropénica. El objetivo es doble: mejorar la sostenibilidad y el bienestar en la ganadería porcina y explorar una solución probiótica y sostenible para combatir la anemia ferropénica en humanos.

Investigadores
- Olga Martín (Agrotecnio-UdL)
- Gemma Bellí (IRBLleida-UdL)
Resumen
Este proyecto estudia cómo ciertos Componentes de las fibras dietéticas y estructures con β-caroteno pueden modular la microbiota intestinal y reducir la inflamación asociada a la obesidad, con el objectivo de desarrollar alimentos funcionales con efectos antiobesidad.